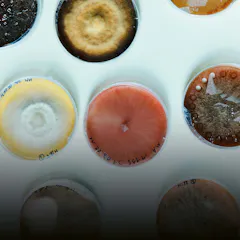

Building bridges for success.
Published on 03/10/2022
Raj Lehal, a molecular biologist by training, has not only sprinted up the academic career ladder at breakneck speed, his scientific skills in the cancer arena quickly blossomed into a keen interest in entrepreneurship.
“Spending hours in the lab analyzing and problem-solving, I have always endeavored to translate my work into tangible clinical assets, helping patients lead fulfilling lives unencumbered by painful ailments,” said Lehal, who has received numerous research fellowships in his native Canada before receiving a Ph.D. degree from the prestigious École Polytechnique Fédérale de Lausanne (EPFL) in 2011.
To sharpen his entrepreneurial skills and get a better grip on the intricacies of the burgeoning biotech sector, Lehal started taking business classes at the EPFL while simultaneously working on his doctoral thesis. “I initially worked with Venturelab, a startup support scheme that brings together key stakeholders in academia and industry to incubate new ideas in an exploratory and multidisciplinary environment,” Lehal explained.
A key partner of Venturelab is Switzerland’s Swissnex platform, whose mission includes, for example, helping startups find a foothold outside Switzerland. “The Swiss-based program proved instrumental in unlocking my full potential and resulted in me being selected to attend a startup bootcamp in Boston organized by Swissnex in 2013.”
As part of a delegation consisting of 20 young Swiss entrepreneurs, Lehal traveled to the United States to pitch his ideas to a group of high-end investors. “Engaging with and getting exposed to the US startup ecosystem broadens one’s perspectives and opens doors to many ventures,” Lehal said. “It was only thanks to Venturelab and Swissnex that I was able to tap into that network.”
Science diplomacy
Swissnex, which is an initiative of the Swiss State Secretariat for Education, Research and Innovation and is part of the Confederation’s network abroad managed by the Federal Department of Foreign Affairs, can trace its roots back to 1958, when Switzerland installed the first science attachés in the United States.
Over the years, the attaché model of science diplomacy was complemented with the idea of full-fledged consulates connecting Switzerland and the world in areas such as education, research and innovation. When Swissnex opened its first office in Boston in 2000, it became the world’s first consulate of this kind.
What initially started as a single office would soon grow into a network spanning the world’s most innovative regions. Besides offices in Boston and San Francisco, Swissnex now has outposts in Brazil, China and India too. It was also very active during the Expo 2020 in Dubai, where Swissnex organized some 40 events with Swiss universities, research institutes, companies and startups.
Most recently, Switzerland has also unveiled plans to open another Swissnex office in Osaka, Japan. In April this year, Swiss Foreign Minister Ignazio Cassis – accompanied by a delegation of Swiss business leaders, including Country President of Novartis Switzerland, Matthias Leuenberger – traveled to Japan amid continued diplomatic efforts to secure new science collaborations across the globe.
During a speech in Kyoto, Cassis underlined the importance of science diplomacy to tackle some of the world’s biggest societal challenges and said that “the international community must take advantage of the opportunities offered by scientific research and make the best decisions for the benefit of humanity.”
Matthias Leuenberger said that Cassis’ efforts were crucial if Switzerland was to continue strengthening its scientific network around the world, especially now that the country is currently treated as a nonassociated third country in Horizon Europe. “Switzerland’s success depends on innovation, which in turn depends on the brightest minds,” Leuenberger said. “This means that Switzerland depends on the free movement of people as well as on Horizon Europe. In the absence of the Horizon program, we now need new avenues to foster ties with other countries.”
Venturing into the United States
With or without a European framework program, Swiss researchers and entrepreneurs have long relied on Swissnex to connect them to innovation hubs like Boston. Beyond fostering scientific collaborations, the institution helps Swiss startups to explore the potential of foreign markets, mainly through its partnership with the Swiss innovation agency Innosuisse.
“We support early-stage entrepreneurs by providing them with insights, contacts, and advice”, said Benjamin Bollmann, who leads the Swissnex offices in Boston and New York. “It’s about stress- testing their business models, facilitating their access to relevant networks, and opening up new opportunities for them.”
While startup markets in Asia and Europe are gaining traction, the United States, the world’s wealthiest economy and home to a thriving startup scene, is still the most popular destination for Swiss entrepreneurs wanting to internationalize their business.
“The venture capital ecosystem in Switzerland has grown significantly over the past 10 years, but it is still relatively young compared to, say, those in Boston or San Francisco,” Bollmann noted.
Also, the mindset is different. “In Switzerland we pride ourselves on the quality of our products and technical inventions. We tend to value humility or think that small is beautiful. This is at odds with the American business ethos, which demands showing ambition and selling a great vision of the future,” Bollmann said, adding that during pitches, asking for too little money often results in American investors casting doubt on the entrepreneur’s determination.
Opening doors
Inducing this mindset change is part of Swissnex’s work, which also includes providing workshops, residencies and other services to interested companies. Raj Lehal, who has sat through numerous pitches in the United States, corroborates Bollmann’s assessment and the importance of Swissnex in this respect.
“In explaining the differences between the European and American mindsets, I use the analogy of a pen. If the Swiss develop a pen, they say, ‘This is the product and this is the price,’ whereas Americans would say, ‘This is the pen and if you buy it, you can write the greatest novel ever.’ American entrepreneurs excel in storytelling and we can learn from them.”
To really get this difference is important and can be a key opener to the road of success. Lehal added: “Imagine you are a recent graduate, lacking the credibility to reach out to major actors in the field. This is when Swissnex comes into play, offering access to a rich web of resources and partners to jumpstart the business.”
One year after winning support from Swissnex, Lehal would create Cellestia, a biopharmaceutical company focusing on cancer and autoimmune disorders. The company successfully extended its operations overseas, with Lehal benefiting from the robust international links Swissnex has nurtured and consolidated over the years.
Going forward
Lehal’s company was one of hundreds Swissnex helped found in the United States and elsewhere. In 2021 alone, the institute supported more than 260 Swiss startups in going global, laying the foundations for a startup and innovation-driven economy.
Given this success, Swissnex will continue in the same vein going forward and provide interested companies with the tools they need.
Amid its latest innovations, Swissnex offices in Boston and New York launched the virtual community platform Founders Coalition. It allows participants and entrepreneurs not only to attend expert sessions, but also to engage in peer-to-peer learning and to share their best practices. This helps them hammer out an adequate strategy to launch a business in the USA.
“As connectors and knowledge brokers, we need to constantly reinvent ourselves and adapt to today’s ever-evolving business environment,” Bollmann said. “Only in this way can we help our partners stay relevant and add value to their ventures in an ever-changing world of technological advancements.”
In a world marred by increasing political and economic conflict as well as fears that globalization is set to slow down, networks such as Swissnex will become increasingly important to keep networks intact. Or, as Cassis put it: “We all depend on an international system that works and recognizes the signs of the times with all their challenges and opportunities.”
You may also be interested in the following:
Thanks for reading Live.Magazine
Stay connected by subscribing to our newsletter
SubscribeBy submitting your email, you consent to Novartis AG collecting and processing your email data for Novartis internal use, in accordance with our privacy policy, and by protected technical means.